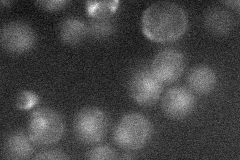
YJL092W
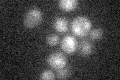
YJL092W

View description
DNA helicase and DNA-dependent ATPase involved in DNA repair, needed for proper timing of commitment to meiotic recombination and transition from Meiosis I to II; blocks trinucleotide repeat expansion; affects genome stability
Localization:
Intensity:
Fold change:
Significance:
-
C’ GFP library in SD

nucleus20.17 -
N' NOP1pr-GFP in SD

punctate,nucleus52.9346 -
N' TEF2pr-mCherry in SD

punctate,nucleus336.231 -
N' NATIVEpr-GFP in SD
nucleus20.263 -
N' TEF2pr-VC and Cyto-VN in SD

nucleus26.8875 -
C’ GFP library in SD+DTT

nucleus14.090.69No -
C’ GFP library in SD+H2O2

nucleus21.011.04No -
C’ GFP library in Starvation Media
nucleus16.390.81No -
C’ GFP library on the background of Pup2-DaMP

nucleus -
C’ GFP library on the background of CCT mutant

nucleus22.18031.09959No
